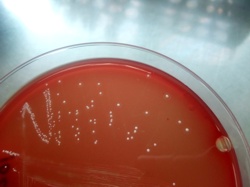

| Staphylococcus capitis weak haemolytic colonies on Sheep Blood Agar |
| Staphylococcus capitis, Gram-stained cells |
| Staphylococcus capitis |
Taxonomy
Morphology
Cultural characteristics
Biochemical characters
Ecology
Pathogenicity
References
Phylum Bacillota (Firmicutes), Class Bacilli, Order Bacillales, Family Staphylococcaceae, Genus Staphylococcus, Staphylococcus
capitis Kloos and Schleifer 1975, two subspecies:
- Staphylococcus capitis subsp. capitis Kloos and Schleifer 1975,
- Staphylococcus capitis subsp. urealyticus Bannerman and Kloos 1991.
capitis Kloos and Schleifer 1975, two subspecies:
- Staphylococcus capitis subsp. capitis Kloos and Schleifer 1975,
- Staphylococcus capitis subsp. urealyticus Bannerman and Kloos 1991.
Gram positive cocci, 0.5 - 1.2 μm, nonmotile, nonspore-forming, singly or grouped in
pairs and clusters.
pairs and clusters.
Colonies are smooth, slightly convex, glistening, opaque, and white or grayish white;
after storage in the cold (4-10 ºC). Some strains become yellowish or yellow-orange.
Colony diameter is 1-3 mm (subsp. capitis) or 4.3-7.1mm ( subsp.urealyticus).
Facultatively anaerobic. optimum growth temperature is 37 ºC. Grows best under
aerobic conditions. Other media: Nutrient agar or nutrient broth, Trypticase Soy Agar ±
5% sheep blood, Mueller Hinton agar, Chapman (selective medium with 75 g/l de
NaCl & mannitol).
after storage in the cold (4-10 ºC). Some strains become yellowish or yellow-orange.
Colony diameter is 1-3 mm (subsp. capitis) or 4.3-7.1mm ( subsp.urealyticus).
Facultatively anaerobic. optimum growth temperature is 37 ºC. Grows best under
aerobic conditions. Other media: Nutrient agar or nutrient broth, Trypticase Soy Agar ±
5% sheep blood, Mueller Hinton agar, Chapman (selective medium with 75 g/l de
NaCl & mannitol).
Isolated from human & animal skin; widely distributed in nature.
Sensible to novobiocin.
Sensible to novobiocin.
- skin surface commensal of man and animals;
- some endocarditis reports, septicemia to neonates;
- nosocomial infections (rarely).
- some endocarditis reports, septicemia to neonates;
- nosocomial infections (rarely).
- Holt J.G., Krieg N.R., Sneath P.H.A., Staley J.T., Wiliams S.T., 1994. Bergey's Manual of Determinative Bacteriology, Ninth Edition,
Williams & Wilkins, Baltimore. Group 17, Gram-Positive Cocci, 527-558. - Kloos W.E. & Schleifer K.H.: Isolation and characterization of staphylococci from human skin. II. Description of four new species:
Staphylococcus warneri, Staphylococcus capitis, Staphylococcus hominis, and Staphylococcus simulans. International Journal of
Systematic Bacteriology, 1975, 25, 62-79. - Bannerman T.L. & Kloos W.E.: Staphylococcus capitis subsp. ureolyticus (sic) subsp. nov. from human skin. Int. J. Syst. Bacteriol.,
1991, 41, 144-147. - Karl-Heinz Schleifer and Julia A. Bell, 2009. Family VIII. Staphylococcaceae fam. nov.. In: (Eds.) P.D. Vos, G. Garrity, D. Jones, N.R.
Krieg, W. Ludwig, F.A. Rainey, K.-H. Schleifer, W.B. Whitman. Bergey’s Manual of Systematic Bacteriology, Volume 3: The
Firmicutes, Springer, 392-426.
See tables for subspecies differential characters.
Positive results for catalase, acid production from: fructose, glucose, mannitol,
mannose & sucrose.
Negative results for alkaline phosphatase, coagulase, clumping factor, heat-stable
nuclease, beta-glucosidase, acid production from: arabinose, cellobiose, melezitose,
raffinose, salicin, trehalose, xylitol & xylose.
Variable results for nitrates reduction & acetoin production.
Positive results for catalase, acid production from: fructose, glucose, mannitol,
mannose & sucrose.
Negative results for alkaline phosphatase, coagulase, clumping factor, heat-stable
nuclease, beta-glucosidase, acid production from: arabinose, cellobiose, melezitose,
raffinose, salicin, trehalose, xylitol & xylose.
Variable results for nitrates reduction & acetoin production.
(c) Costin Stoica

| Antibiogram |
| Encyclopedia |
| Culture media |
| Biochemical tests |
| Stainings |
| Images |
| Movies |
| Articles |
| Identification |
| Software |
| R E G N U M PROKARYOTAE |
| Back |
|
|
|